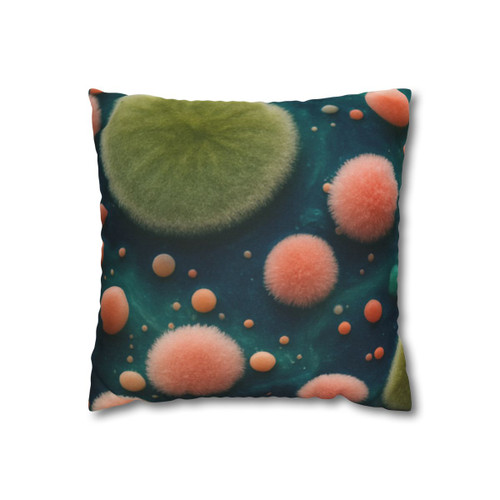
Microbial Galaxy - Spun Polyester Square Pillowcase

Product Overview
Transform your living space into a celestial retreat with the "Microbial Cosmos" Spun Polyester Square Pillowcase. Featuring a captivating cosmic design, this pillowcase not only enhances your decor but also provides a soft, protective layer for your pillows. Crafted from durable spun polyester, it’s perfect for adding a touch of style and personalization to your daily carry items. Express your unique personality while ensuring comfort and protection for your devices. Ideal for any setting, this pillowcase will inspire cozy evenings and rejuvenating rest. Elevate your space with artful functionality!
Product features
- 100% spun polyester for durability and shape retention
- Beige plastic zipper with a stylish metal head
- Double-sided print for versatile styling
- Concealed zipper for a seamless look
- Pre-constructed item with size variance of +/- 0.5"
Care instructions
- Remove the pillows cover if it's removable. Pre-treat the stains with soft cloth or bristle brush that had been soaked in warm soap water. Machine wash, max 40°C, normal cycle. Do not bleach, do not tumble dry. Iron, steam or dry low heat only. Do not dry-clean. Fluff to reshape when assembled back together.
| 14" × 14" | 16" × 16" | 18" × 18" | 20" × 20" | |
|---|---|---|---|---|
| Width, in | 14.00 | 16.00 | 18.00 | 20.00 |
| Length, in | 14.00 | 16.00 | 18.00 | 20.00 |